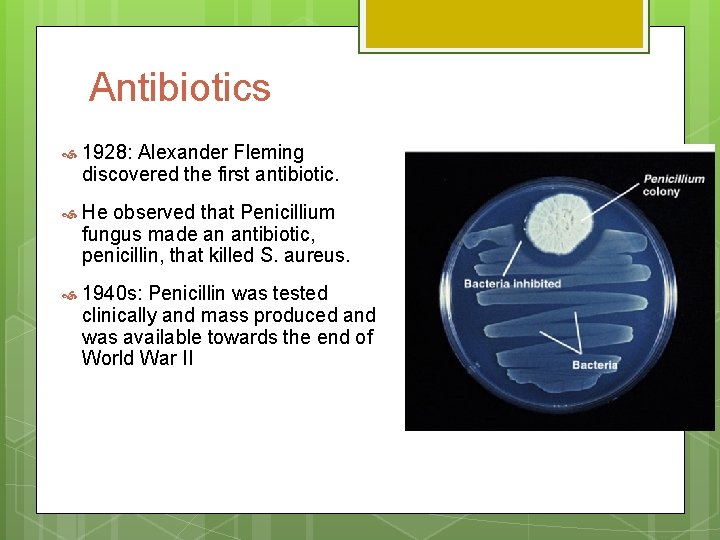
Antibiotics 1928: Alexander Fleming discovered the first antibiotic. He observed that Penicillium fungus made

Medical Microbiology The History What is Microbiology It

Medical Microbiology The History

What is Microbiology? It is the study of microbes or microorganisms Microbes, or microorganisms are minute living things that are usually unable to be viewed with the naked eye.

What is Microbiology continued What are some examples of microbes? Bacteria, fungi, protozoa, algae, viruses, and some are parasites (helminths) Some are pathogenic Microbiology also involves processes that include immunology, epidemiology, bacterial physiology

History of Microbiology First microbes were observed in 1673 Robert Hooke- In 1665 reported that living things were composed of little boxes or cells devised system the compound microscope and illumination Antoni van Leeuwenhoek- (1673 -1723) He is considered the father of bacteriology Made simple microscopes and began observing with them Discovered bacteria (he called them animalcules)

Leeuwenhoek's microscope consisted simply of: A) a screw for adjusting the height of the object being examined B) a metal plate serving as the body C) a skewer to impale the object and rotate it D) the lens itself, which was spherical

History of Microbiology Many believed in spontaneous generation: Aristotle synthesized the hypothesis which stated that some vital force contained in given to organic matter can create living organisms from inanimate objects. In basic terms spontaneous generation stated that living organisms arise from non living matter.

History of Microbiology Spontaneous generation was disproved in 1668 by Italian Scientist, Francesco Redi.

History of Microbiology John Needham- revived theory of spontaneous generation in 1745 Needham theorized that if he took chicken broth and heated it, all living things in it would die. After heating some broth, he let a flask cool and sit at a constant temperature. The development of a thick turbid solution of microorganisms in the flask was strong proof to Needham of the existence of spontaneous generation. Lazzaro Spallanzani (1729 -1799) He demonstrated that microorganisms were already in the solution, the container, or the air He took solutions which he knew would "breed" organisms and boiled them for up to an hour. The flasks were hermetically sealed to keep out contaminated air.

History of Microbiology Theory of biogenesis later arose In 1858 German scientist, Rudolf Virchow challenged spontaneous generation with his concept of biogenesis Living Virchow organisms arise from pre-existing life presented his idea to the scientific community, but could not back it up with a convincing experiment

History of Microbiology In 1861, a French scientist by the name of Louis Pasteur demonstrated where microorganisms came from Father of Medical Microbiology Demonstrated the microorganisms exist in the air and could contaminate sterile solutions by passing air through cotton filters The filter trapped tiny particles floating in the air http: //www. microbiologytext. com/index. php? module=Book&func=displayarticle&art_id=27

History of Microbiology Louis Pasteur performed numerous experiments to discover why wine and dairy products became sour He found that bacteria were to blame Pasteur called attention to the importance of microorganisms in everyday life and stirred scientists to think that if bacteria could make the wine “sick, ” then perhaps they could cause human illness.

Louis Pasteur’s Swan neck flask experiment http: //www. microbiologytext. com/index. php? module=Book&func=displayarticle&art_id=27

Golden Age of Microbiology 1857 - 1914 Beginning with Pasteur’s work, discoveries included the relationship between microbes and disease, immunity and antimicrobial medicine Germ theory of disease Pasteur showed that microbes are responsible for fermentation Microbial growth is also responsible for spoilage of food Pasteur demonstrated that spoilage bacteria could be killed with heat (pasteurization) Developed vaccines for anthrax (1881)and rabies (1885)

Germ theory disease 1835: Agostino Bassi- showed a silkworm diseases was caused by a fungus 1865: Pasteur- believed that another silkworm disease was caused by a protozoan 1840 s: Ignaz Semmelwise- advocated hand washing to prevent transmission of fever from one OB patient to another

Germ theory disease 1860 s: Joseph Lister- He is the father of antiseptic surgery. He used a chemical disinfectant (carbolic acid) to prevent surgical wound infections after Pasteur’s work showing microbes are in the air, can spoil food, and cause animal disease. 1867: Robert Koch- provided proof that bacterium causes anthrax and provided the experimental steps, Koch’s postulates, used to prove that a specific microbe causes a specific disease.

Koch’s postulates Pathogen must be present in all cases of disease Pathogen must be isolated and grown in lab in pure culture Pathogen from pure cultures must cause disease when inoculated into healthy, susceptible lab animal Same pathogen must be isolated from the diseased lab animal

History of Vaccination A precursor of smallpox vaccination was variolation An early Asian method which introduced dried scabs of smallpox patients and was later modified in Europe Modification consisted of injecting infectious material under the skin First tested among abandoned children and prisoners When it was declared safe, members of the English royal family were inoculated

Vaccination continued: 1796: Edward Jenner is credited with the development of the smallpox vaccine Folk wisdom suggested that dairy maids who had contracted cowpox seemed to be immune to smallpox Infection with the cowpox virus produced a much less sever form of disease that smallpox

Vaccination continued Jenner conducted an experiment in which he used scabs from the cowpox lesions on the arm of a dairy maid, Sarah Nelmes to create a small pox vaccine He then used the material to vaccinate an 8 year old boy, James Phipps After being vaccinated Phipps appeared to develop immunity to the smallpox virus.

Vaccination continued Later Jenner vaccinated his own son and several other children He obtained similar results Worldwide elimination of smallpox was achieved in 1978 Called The vaccination from vacca for cow protection is called immunity
Antibiotics 1928: Alexander Fleming discovered the first antibiotic. He observed that Penicillium fungus made an antibiotic, penicillin, that killed S. aureus. 1940 s: Penicillin was tested clinically and mass produced and was available towards the end of World War II

Development of Agar Angelina Hesse developed the use of Agar to grow microorganisms. She was the wife of Walter Hesse who worked in Koch’s laboratory Advantages of agar- It was not attacked by most bacteria. Agar is better than gelatin because of its higher melting point (96°c) and solidifying (40– 45°c) points.

Petri Dish Richard Petri (1887) He developed the Petri dish (plate), a container used for solid culture media
- Slides: 23